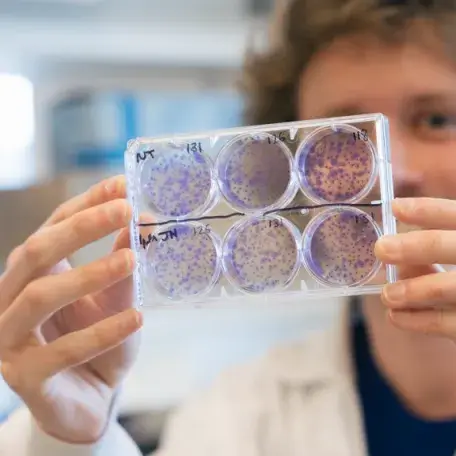

A top 100, R1 public research university in the United States, UVM is home to over 1,200 full-time faculty scholars. From biomedical research to philosophy, from data science to musical composition, our faculty members engage daily in the pursuit of meaningful and impactful research, scholarship and creative work.
Research Feature: Anna Maassel
Find It Fast
Research by the Numbers
- 1000+ Faculty and research projects started (FY 2024)
- $225M in extramural support for advanced research (FY25)
- >2x growth in research funding in just five years
- Top 10 "Most Innovative Tech Hub" - Forbes
More than 100 staff and faculty members dedicated to the pursuit of meaningful and impactful research, scholarship, and creative work.
Research Offices
Research by College
- College of Engineering and Mathematical Sciences (CEMS)
- College of Education and Social Services (CESS)
- College of Nursing and Health Sciences (CNHS)
- College of Agriculture and Life Sciences (CALS)
- College of Arts and Sciences (CAS)
- Rubenstein School of Environment and Natural Resources (RSENR)
- Larner College of Medicine (LCOM)
Research News

Who Gets to Choose a Plant‑Based Diet?
RISE Summit 2026 Explores "Rural Prosperity" with University and Community Participants
Research Feature: Anna Maassel and Wildfire Smoke's Effects on Childhood Asthma
The promise and pitfalls of monitoring harmful algal blooms with remote sensing
Mount Mansfield: A Hub for Recreation and Research
WRI Announces Awards to Support Collaborative Research & Career Development